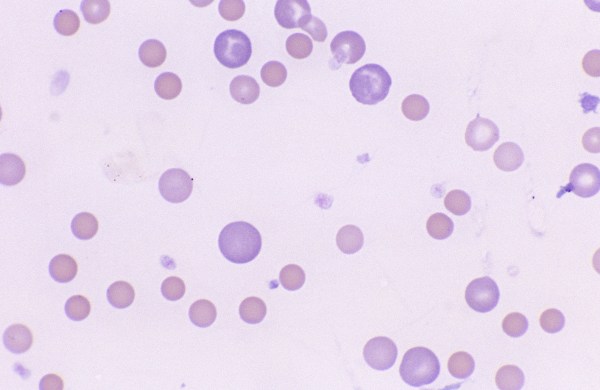

Anisocytosis
Morphology: variation in red blood cell size due to the presence of red cells larger than normal (macrocytes and polychromatophils), red cells smaller than normal (microcytes and spherocytes), or both. Commonly… Read more Anisocytosis →
Morphology: variation in red blood cell size due to the presence of red cells larger than normal (macrocytes and polychromatophils), red cells smaller than normal (microcytes and spherocytes), or both. Commonly… Read more Anisocytosis →

Morphology: red blood cells that are smaller than normal. May be hypochromic or normochromic. Central pallor is preserved (in dogs). Look alike: spherocytes (may be difficult to distinguish spherocytes from microcytes in… Read more Microcytes →